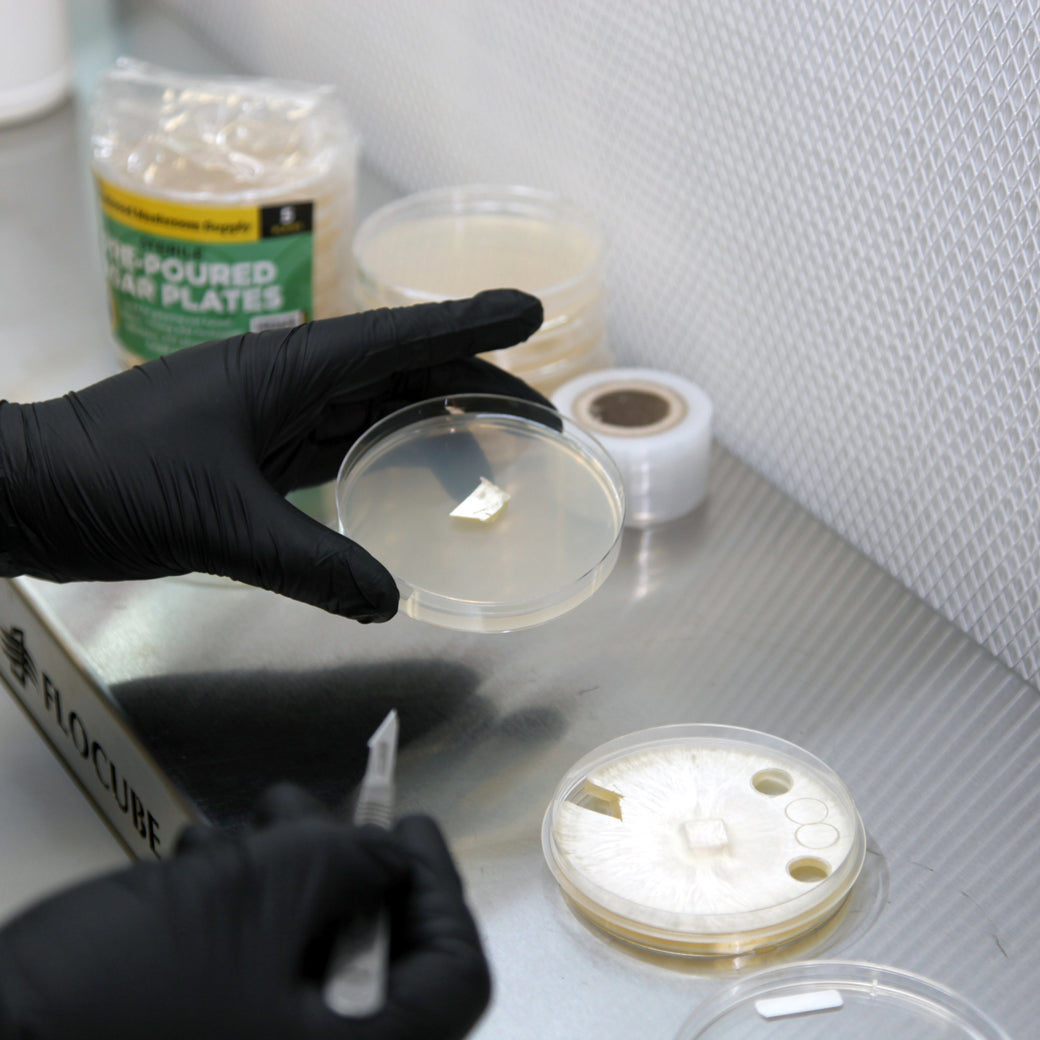
Redwood Mushroom Supply Sterile Pre-Poured Agar Plates - Pack of 5

From locating the product through receipt of package, the whole process was well organized. Shipping cost was reasonable and delivered quickly. THANK YOU!
NEVER shop here, they didn't send the right product, and are now insisting that we pay $100 restocking fee + $60 on shipping (meaning we don't get any money back).
I will never recommend or shop here again.
$38 for ice and a small little sachet. For the same price I could get 30 sachets directly from the source don't trust these guys! Go to TipTopbio.com the website listed on the sachet!
First time last time customer. These guys are definitely cut off!
The timing of the delivery is extremely expedient, and the beneficial nematodes are very effective. I will definitely purchase from this company again and I highly recommend their beneficial nematodes.